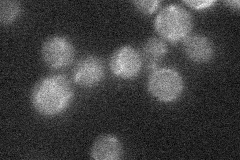
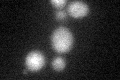
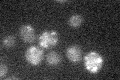

View description
Subunit of a heterodimeric peroxisomal ATP-binding cassette transporter complex (Pxa1p-Pxa2p), required for import of long-chain fatty acids into peroxisomes; similarity to human adrenoleukodystrophy transporter and ALD-related proteins
Localization:
Intensity:
Fold change:
Significance:
-
C’ GFP library in SD

below threshold15.29 -
N' NOP1pr-GFP in SD

punctate25.1418 -
N' TEF2pr-mCherry in SD

punctate6.99294 -
N' NATIVEpr-GFP in SD
below threshold19.3132 -
N' TEF2pr-VC and Cyto-VN in SD

#N/A0 -
C’ GFP library in SD+DTT
cytosol15.61.01No -
C’ GFP library in SD+H2O2

cytosol16.591.08No -
C’ GFP library in Starvation Media
cytosol17.161.12No -
C’ GFP library on the background of Pup2-DaMP

below threshold -
C’ GFP library on the background of CCT mutant

below threshold14.2720.932632No
